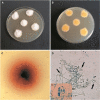

Dermatophytosis caused by Nannizzia nana (Microsporum nanum): a comprehensive review on a novel pathogen
- PMID: 36437438
- PMCID: PMC9943922
- DOI: 10.1007/s42770-022-00880-5
Dermatophytosis caused by Nannizzia nana (Microsporum nanum): a comprehensive review on a novel pathogen
Abstract
Keratinophilic fungi are mostly soil-inhabiting organisms with occasional infections in humans and animals. Even though most dermatophytes are host-adapted, cross-species infections are common by zoophilic and geophilic dermatophytes. N. nana is considered an etiological agent of ringworm in pigs but has also been isolated from other animals, including humans. However, it also possesses many characteristics of geophilic dermatophytes including the ability to grow in soil. N. nana produces characteristic pear-shaped macroconidia and usually exhibits an ectothrix pattern of hair infection. It has been isolated from dermatitis lesions as well as from soil. N. nana infections in pigs are not of much concern as far as economy or health is concerned. But it has been associated with onychomycosis and gonathritis in humans, which are significant in human medicine. The shift in the predominance of dermatophytes in humans and the ability to evolve into a potential tinea pathogen necessitates more understanding of the physiology and genetics of N. nana. In this review, we have attempted a detailed analysis of the studies about N. nana, emphasizing growth and cultural characters, physiology, isolation, infection in humans and animals, molecular characterization and antifungal susceptibility.
Keywords: Cross-species infection; Dermatophytes; Microsporum nanum; Nannizzia nana; Ringworm; Skin disease.
© 2022. The Author(s) under exclusive licence to Sociedade Brasileira de Microbiologia.
Conflict of interest statement
The authors declare that they have no competing interests.
Figures

References
-
- Novak EK, Galgoczy J. Notes on dermatophytes of soil origin. Mycopathologia et mycologiaapplicata. 1966;28(4):289–296. doi: 10.1007/BF02145099. - DOI
-
- Gräser Y, El Fari M, Vilgalys R, Kuijpers AFA, De Hoog GS, Presber W, Tietz HJ (1999) Phylogeny and taxonomy of the family Arthrodermataceae(dermatophytes) using sequence analysis of the ribosomal ITS region. Med Mycol 37(2):105–114 - PubMed
-
- Deshmukh SK. Incidence of dermatophytes and other keratinophilic fungi in the glacier bank soils of the Kashmir valley India. Mycologist. 2002;16(4):165–167. doi: 10.1017/S0269915X0200407X. - DOI
Publication types
MeSH terms
Substances
Supplementary concepts
LinkOut - more resources
Full Text Sources